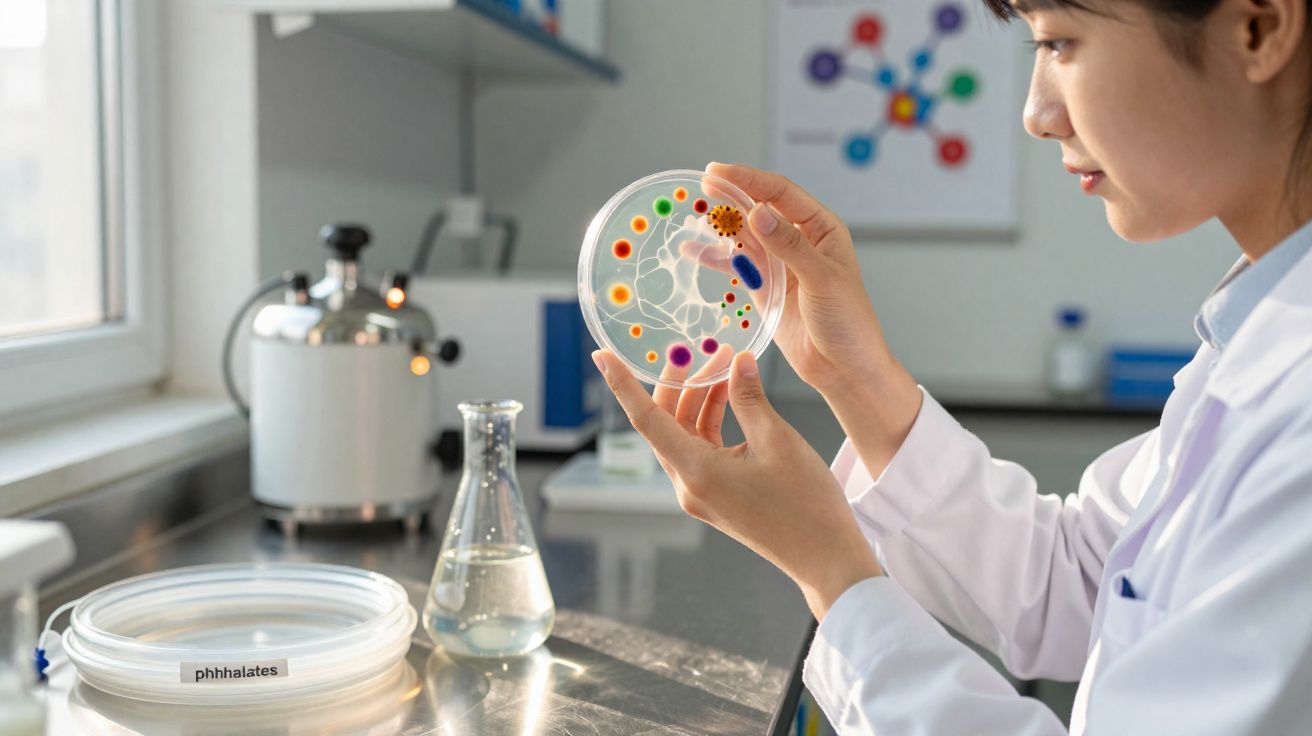
Mulher em laboratório a analisar placa de Petri com colónias bacterianas coloridas à luz natural.

Em laboratórios na China, uma equipa de investigação observou uma comunidade invulgar de bactérias capaz de decompor, em conjunto, plastificantes de plástico que, até agora, as espécies isoladas não conseguiam degradar por completo. Este trabalho aponta um caminho para, no futuro, descontaminar solos e massas de água de forma muito mais suave e sustentável do que os métodos químicos dispendiosos usados actualmente.
Perigo invisível nos plásticos flexíveis: ftalatos e plastificantes
Isolamentos de cabos flexíveis, cortinas de duche, pavimentos vinílicos, tubos usados em cuidados intensivos, embalagens alimentares: em todos estes produtos existem plastificantes, sobretudo os chamados ftalatos. São eles que mantêm o plástico maleável - mas, com o tempo, libertam-se lentamente do material e acabam por entrar no ambiente.
Quando já se encontram no exterior, espalham-se pelo ar, pela água e pelo solo. Os rios transportam-nos para lagos e zonas costeiras; a partir de solos contaminados, podem migrar para águas subterrâneas e para áreas agrícolas. Estas moléculas não se vêem nem se cheiram, mas persistem durante anos a décadas.
Muitos estudos indicam que os ftalatos podem interferir com o sistema hormonal em pessoas e animais. É precisamente por isso que a sua ampla disseminação preocupa especialistas há muito tempo - em particular porque são compostos relativamente estáveis e, para a maioria dos microrganismos naturais, a degradação fica incompleta.
Porque é que a descontaminação clássica chega ao limite
Para reabilitar locais muito poluídos, as soluções mais usadas continuam a ser físicas e químicas: escavar o solo, lavar, aquecer, tratar com reagentes, ou fazer passar a água por carvão activado ou resinas. Resulta, mas exige muito investimento, energia e tempo.
- investimento elevado em grandes instalações e infra-estruturas
- consumo energético significativo para aquecimento, bombagem e pressurização
- produção de novos resíduos que também têm de ser tratados e eliminados
- aplicabilidade limitada em áreas remotas ou em zonas muito extensas
Em paralelo, investigadores procuram há anos alternativas biológicas. A ideia é que microrganismos transformem poluentes em substâncias inofensivas e naturalmente presentes. Para alguns químicos, certas bactérias já o fazem com eficácia; porém, no caso dos ftalatos, os resultados foram durante muito tempo desanimadores. Nenhuma espécie, sozinha, conseguia concluir toda a sequência de degradação.
A solução inesperada: um consórcio bacteriano para degradar plastificantes
Em vez de continuarem à procura de uma “bactéria milagrosa” que resolvesse tudo por si, os investigadores optaram por outra abordagem: analisaram comunidades microbianas provenientes de amostras ambientais contaminadas. Nessas amostras, identificaram um consórcio bacteriano no qual várias espécies cooperam de forma estreita.
"O estudo mostra: só a cooperação de bactérias especializadas torna possível a degradação completa dos plastificantes."
Cada espécie assume um passo bem definido, como numa cadeia microbiana de transformação:
- Um primeiro grupo corta as grandes moléculas de plastificante em fragmentos mais pequenos.
- Outras espécies continuam a metabolizar esses produtos intermédios, que por si só muitas vezes ainda são estáveis ou até tóxicos.
- Um terceiro conjunto de microrganismos converte os últimos resíduos em compostos simples que entram no metabolismo normal das células.
Nenhuma destas espécies, isoladamente, possui todas as enzimas necessárias. Só em conjunto surge um percurso contínuo - do poluente persistente até substâncias como piruvato ou succinato, que as células usam na produção de energia.
Divisão de tarefas precisa em vez de um “faz-tudo”
Os autores descrevem esta rede como uma linha de montagem à escala de micrómetros: se uma etapa falha, toda a sequência abranda. Nessa situação, certos intermediários podem acumular-se e intoxicar as próprias bactérias. Quando o consórcio está funcional, esses compostos são imediatamente consumidos e transformados.
Também é notável o grau de adaptação entre parceiros. Algumas bactérias, em laboratório, só crescem de forma consistente quando existem produtos metabólicos libertados pelas vizinhas. A especialização tornou-se tão marcada que, sem o restante grupo, têm dificuldade em sobreviver.
Este “cross-feeding” - a alimentação mútua via compostos intermédios - torna o consórcio especialmente eficiente: há poucas perdas de nutrientes, subprodutos indesejados desaparecem rapidamente e a comunidade aproveita ao máximo os recursos disponíveis.
O percurso químico: do plastificante ao “combustível” celular
Quimicamente, os ftalatos pertencem ao grupo dos ésteres. Essa estrutura dá estabilidade aos plásticos - e, ao mesmo tempo, torna-os difíceis de atacar. O caminho de degradação descrito pelos investigadores pode ser organizado em três fases gerais:
Ruptura das ligações éster
Enzimas removem primeiro cadeias laterais da estrutura base da molécula. Formam-se compostos mais pequenos e, entre outros produtos, ácido ftálico.Transformação do ácido ftálico
Bactérias especializadas convertem esse ácido em substâncias como o ácido protocatecuico. Aqui é onde muitas espécies isoladas falham; no consórcio, a etapa seguinte é assumida por outro parceiro.Integração em vias metabólicas centrais
Outras bactérias abrem por completo a estrutura em anel que ainda resta e encaminham os fragmentos para o metabolismo energético - por exemplo, sob a forma de piruvato ou succinato.
Cada etapa exige um conjunto próprio de enzimas. O estudo evidencia ainda a sensibilidade do sistema: se o equilíbrio entre espécies ou a disponibilidade de nutrientes se altera, as reacções podem perder sincronização.
Como aplicar estas descobertas no terreno
As implicações não se limitam ao laboratório. O conceito é pensado para utilização em locais reais: áreas industriais contaminadas, estações de tratamento de águas residuais, aterros, bem como sedimentos em portos ou rios. Nesses contextos, comunidades bacterianas deste tipo poderiam ser introduzidas de forma dirigida - ou, em alternativa, poderiam ser favorecidos microrganismos já presentes.
Face às abordagens tradicionais, este caminho oferece várias vantagens:
- menor consumo de energia, por dispensar temperaturas e pressões elevadas
- melhor integração com ecossistemas existentes
- possibilidade de auto-regulação a longo prazo, se a comunidade se estabelecer localmente
- menos auxiliares químicos e, consequentemente, menos resíduos novos
Nas primeiras propostas, especialistas apontam para filtros bioactivos, biorreactores ou tratamentos de solo ajustados. Uma opção seria fornecer nutrientes ou oxigénio às comunidades microbianas do próprio solo, de modo a que os consórcios úteis ganhem vantagem e acelerem o processo.
Obstáculos em condições reais
Ainda assim, não é um processo sem dificuldades. Cada local tem condições distintas: temperatura, pH, salinidade, disponibilidade de oxigénio e competição com outros microrganismos podem afectar fortemente a actividade das bactérias.
Na prática, isso significa que os consórcios terão de ser adaptados às condições locais - ou concebidos para serem suficientemente robustos para lidar com variações. Os investigadores estão a analisar até que ponto estas cooperações se mantêm estáveis ao longo do tempo e como as espécies se modificam dentro da comunidade quando são introduzidas em solos ou massas de água naturais.
O que convém saber sobre ftalatos e biorremediação
Hoje, os ftalatos surgem em muitas amostras ambientais - desde rios próximos de grandes cidades até regiões remotas. Para particulares, não é simples medir a exposição, mas é possível reduzir o risco pessoal: preferir produtos de plástico com menos odor intenso em casa, manusear com cuidado pavimentos antigos de PVC ou cortinas de duche envelhecidas e fazer escolhas mais criteriosas ao comprar brinquedos para crianças.
Ainda assim, a alavanca principal está na indústria e na regulação. Se os plastificantes forem libertados mais lentamente pelos produtos, ou se forem substituídos por alternativas menos problemáticas, diminui a pressão sobre o ambiente e sobre as infra-estruturas de tratamento. Métodos biológicos como o consórcio bacteriano agora estudado funcionariam então como uma linha adicional de segurança para reduzir contaminações já existentes.
De forma geral, biorremediação é o uso de seres vivos - sobretudo microrganismos e plantas - para limpar locais contaminados. Pode envolver bactérias em aquíferos, fungos em solos poluídos ou faixas de caniçal em lagoas de tratamento. A abordagem descrita aqui pertence às variantes mais exigentes, porque aposta deliberadamente em comunidades finamente ajustadas, em vez de depender de uma única espécie “resistente”.
A longo prazo, equipas bacterianas deste tipo poderão também ser úteis para outros poluentes, como pesticidas, solventes ou componentes provenientes do desgaste de pneus. Muitas dessas substâncias podem ser quebradas quimicamente em blocos pequenos que os microrganismos conseguem aproveitar. Quanto melhor se compreender a divisão de tarefas e a comunicação dentro destes consórcios, mais precisamente será possível adaptá-los a novas funções - incluindo comunidades “à medida” para passivos ambientais particularmente difíceis.

Comentários
Ainda não há comentários. Seja o primeiro!
Deixar um comentário